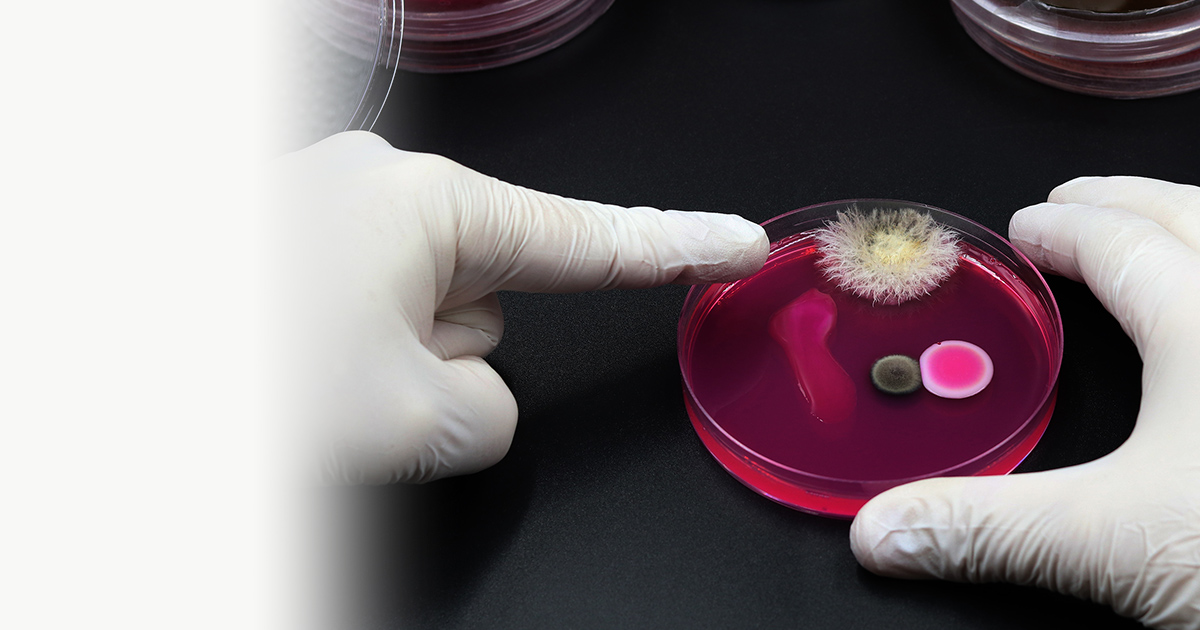
製品・サービス | 食品・環境検査分野 衛生管理関連サイト コスモ会

フィシオエナジェティック 生体化学物質基本テストキット シリカ化学検査テストキット- HI38067【医薬用外劇物】
(3012件)
Pontaパス特典
サンキュー配送
24750円(税込)
248ポイント(1%)
Pontaパス会員ならさらに+1%ポイント還元!
送料
(
)
3002
配送情報
お届け予定日:2026.04.15 17:53までにお届け
※一部地域・離島につきましては、表示のお届け予定日期間内にお届けできない場合があります。
ロットナンバー
2467672297
お買い物の前にチェック!

Pontaパス会員なら
ポイント+1%
ポイント+1%
商品説明




フィシオエナジェティックの検査で使う生体化学物質基本テストキットになります。購入してからアンプルは開けたりしていませんし、基本的には暗所常温で保管しておりました。ペットや喫煙はありません。しかし絶対的な品質の保証は出来ませんので、その点をご了承の上でご検討ください。このテストキットは現在ショップがなく、入手困難かと思います。市場に出ることも滅多にないので、ご興味のある方はこの機会に是非ご検討ください。ご覧いただきありがとうございます。
| カテゴリー: | 本・雑誌・漫画>>>本>>>健康・医学 |
|---|---|
| 商品の状態: | 目立った傷や汚れなし","細かな使用感・傷・汚れはあるが、目立たない |
| 配送料の負担: | 送料込み(出品者負担) |
| 配送の方法: | 佐川急便/日本郵便 |
| 発送元の地域: | 大分県 |
| 発送までの日数: | 2~3日で発送 |
レビュー
商品の評価:




 5.0点(3012件)
5.0点(3012件)
- ウサギ456
- 他の方のレビューに、登場する野菜がマイナーとあり、迷いながら購入しました。 私的には、レースの勝者は、(ストーリーにあまり関係ないかもですが、)唐辛子やトウモロコシなのは....てす。大根やにんじんも出てきますが、観客で、他の選手もセロリやパセリと、一般的な野菜の名前を覚えさせようと買ったので残念です。 ダジャレも私のつぼにはハマらないようです。 が!!なぜだか???娘は大好きなようで、家の中を持って歩いてます。 絵がかわいいからかな?ストーリーより野菜辞典になってます。 わからないですね..........。
- yuzi98
- 色んな読み方をして興味を持たせています。 日常に出てくる擬音が多くてgood。 厚紙なのもgood。自分でページをめくりたがります。 なめてもふけるのもいいですね。
- しかおqowop
- ムーミンファン公式ブックの中で紹介されていた、絵本でしたので、つい全部そろえてみたくなりました。 本まで手を出してしまうと、やばいです^^;
- saaachan0620
- スタートゥインクルプリキュアにハマっている娘へ購入。ひらがなを読めるようになってきたので頑張って読みながら歴代のプリキュアも覚えようとしています。私自身ハートキャッチプリキュアを観ていたので懐かしくもあり、いろんなのが居るなぁと楽しめています。
- epponita
- 6か月の甥に購入。 もっと早く買ってあげたらよかった!はっきりした色合いと可愛らしい表情に目をまるくして見入っていました。 分厚い紙でよだれだらけにしてもさっとふけば平気なので、赤ちゃんに一人読書をさせてみました。 自分で頑張ってめくって読んでいました。
- お兄さんその1
- 音の数も多いし曲を流すボタンも大きくて押しやすいし機能はいいです!鍵盤がピカピカ光るのも喜んでます! ひかりのガイドで楽しく弾けるとありますが、鍵盤を押すと次の音が光るのではなく、曲にあわせて光るだけなので、これでは子供は弾けません!押すまで待って欲しい! スピードボタンも毎回押さなきゃいけないのが面倒。固定できたらいいのに。 それ以上にすぐ壊れたのがマイナスポイントです。確か1ヶ月もしないうちに壊れはじめ、だましだまし使ってたら交換のタイミングを逃しました。電源を入れるとメロディが鳴るのですがひたすらなってます。止まっても曲の途中で突然なったり、和音を押すとなります。 楽譜も切り取ってしまったし、最初は使えていたから初期不良ではないのかな??交換は難しいかなと思って諦めました。とても楽しいピアノ絵本なのに…購入される方はしばらく様子を見て怪しいなと思ったらすぐに交換をオススメします。 子供が使うものなので叩いたり落としたりあると思います。それに耐えられるよう丈夫に作って欲しかった。。。 今日思い立って電池を1回抜いてみてもダメだったのでレビュー投稿します。 壊れさえしなければ、とってもいい商品です!
- jintarosu0223
- 値段もそれなりでページ数もあるわりに内容はイマイチ。ちょっと損した気分です。
すべて見る
お店の情報
7,367
連絡・応対
4.3
配送スピード
4.3
梱包
4.3